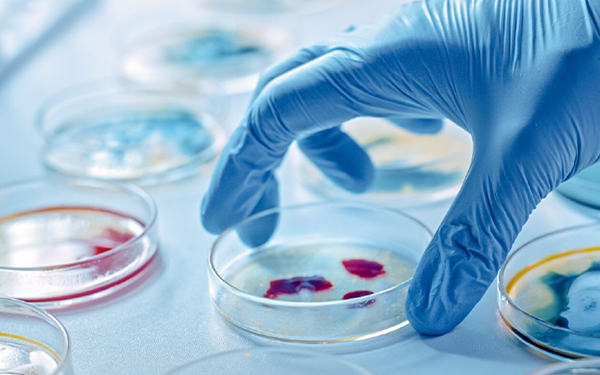
MICRO BIOLOGY

Precision, expertise, care - Svscans, your reliable diagnostic partner
Thousand+ patients test with us every month
Machines with high resolution from Siemens
ISO and NABL Diagnosis center
10+ Radiologists to ensure fast and accurate reporting
Dual check on all reports for 100% accuracy assurance
Enhanced MRI & CT reporting for additional findings
Unlock unique advantages for your health with SVScan's exclusive benefits
Dedicated support to find best centers
Get extra discount on the blood tests
Assured discount on your scan in any center
Get Priority appointment for your scans
Quickly and easily book your lab appointment online or by phone
Leave your name & phone number with us
We will reach out to you to understand your requirements.
Lab details & charges will be shared with you over the call.
We’ll book your test as per your preferred date and time slot.
Find answers to common questions about our services, treatments, appointments, and patient care options to help you make informed health decisions.

Designed by We Touch Technologies 2024 All Rights Reserved.